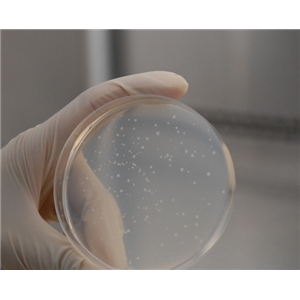
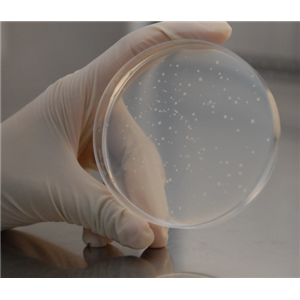
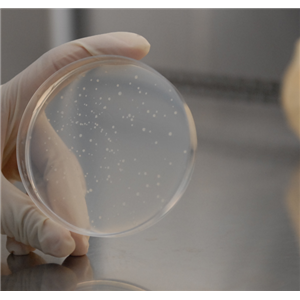

6YR企业会员
 SD大鼠肠微粒体 Rat Intestinal Microsomes
SD大鼠肠微粒体 Rat Intestinal Microsomes
¥34 元
更新时间:2026/02/28
大鼠肠微粒体 Rat Intestinal Microsomes
大鼠肠微粒体 Rat Intestinal Microsomes
¥10 元
更新时间:2026/02/28
比格犬肠微粒体 Beagle Dog Intestinal Microsomes
比格犬肠微粒体 Beagle Dog Intestinal Microsomes
¥26 元
更新时间:2026/02/28
食蟹猴肠微粒体 Monkey Intestinal Microsomes
食蟹猴肠微粒体 Monkey Intestinal Microsomes
¥25 元
更新时间:2026/02/28
 猴肠微粒体 Monkey Intestinal Microsomes
猴肠微粒体 Monkey Intestinal Microsomes
¥1000 元
更新时间:2026/02/28
 人肠微粒体 Human Intestinal Microsomes
人肠微粒体 Human Intestinal Microsomes
¥4000 元
更新时间:2026/02/28
 KM小鼠肝微粒体 Mouse Liver Microsomes
KM小鼠肝微粒体 Mouse Liver Microsomes
¥400 元
更新时间:2026/02/28
 C57小鼠肝微粒体 Mouse Liver Microsomes
C57小鼠肝微粒体 Mouse Liver Microsomes
¥78 元
更新时间:2026/02/28
 ICR/CD-1小鼠肝微粒体 Mouse Liver microsomes
ICR/CD-1小鼠肝微粒体 Mouse Liver microsomes
¥400 元
更新时间:2026/02/28
 Wistar Han大鼠肝微粒体 Rat Liver Microsomes
Wistar Han大鼠肝微粒体 Rat Liver Microsomes
¥23 元
更新时间:2026/02/28
 Wistar大鼠肝微粒体 Rat Liver Microsomes
Wistar大鼠肝微粒体 Rat Liver Microsomes
¥200 元
更新时间:2026/02/28
 狗肝微粒体 Dog Liver Microsomes
狗肝微粒体 Dog Liver Microsomes
¥980 元
更新时间:2026/02/28
 恒河猴肝微粒体 Rhesus Monkey Liver Microsomes
恒河猴肝微粒体 Rhesus Monkey Liver Microsomes
¥1980 元
更新时间:2026/02/28
 食蟹猴肝微粒体 Cynomolgus Monkey Liver Microsomes
食蟹猴肝微粒体 Cynomolgus Monkey Liver Microsomes
询价
更新时间:2026/02/28
 猴肝微粒体 Monkey Liver Microsomes
猴肝微粒体 Monkey Liver Microsomes
¥25 元
更新时间:2026/02/28
 人肝微粒体 HLM/Human Liver Microsomes
人肝微粒体 HLM/Human Liver Microsomes
¥100 元
更新时间:2026/02/28